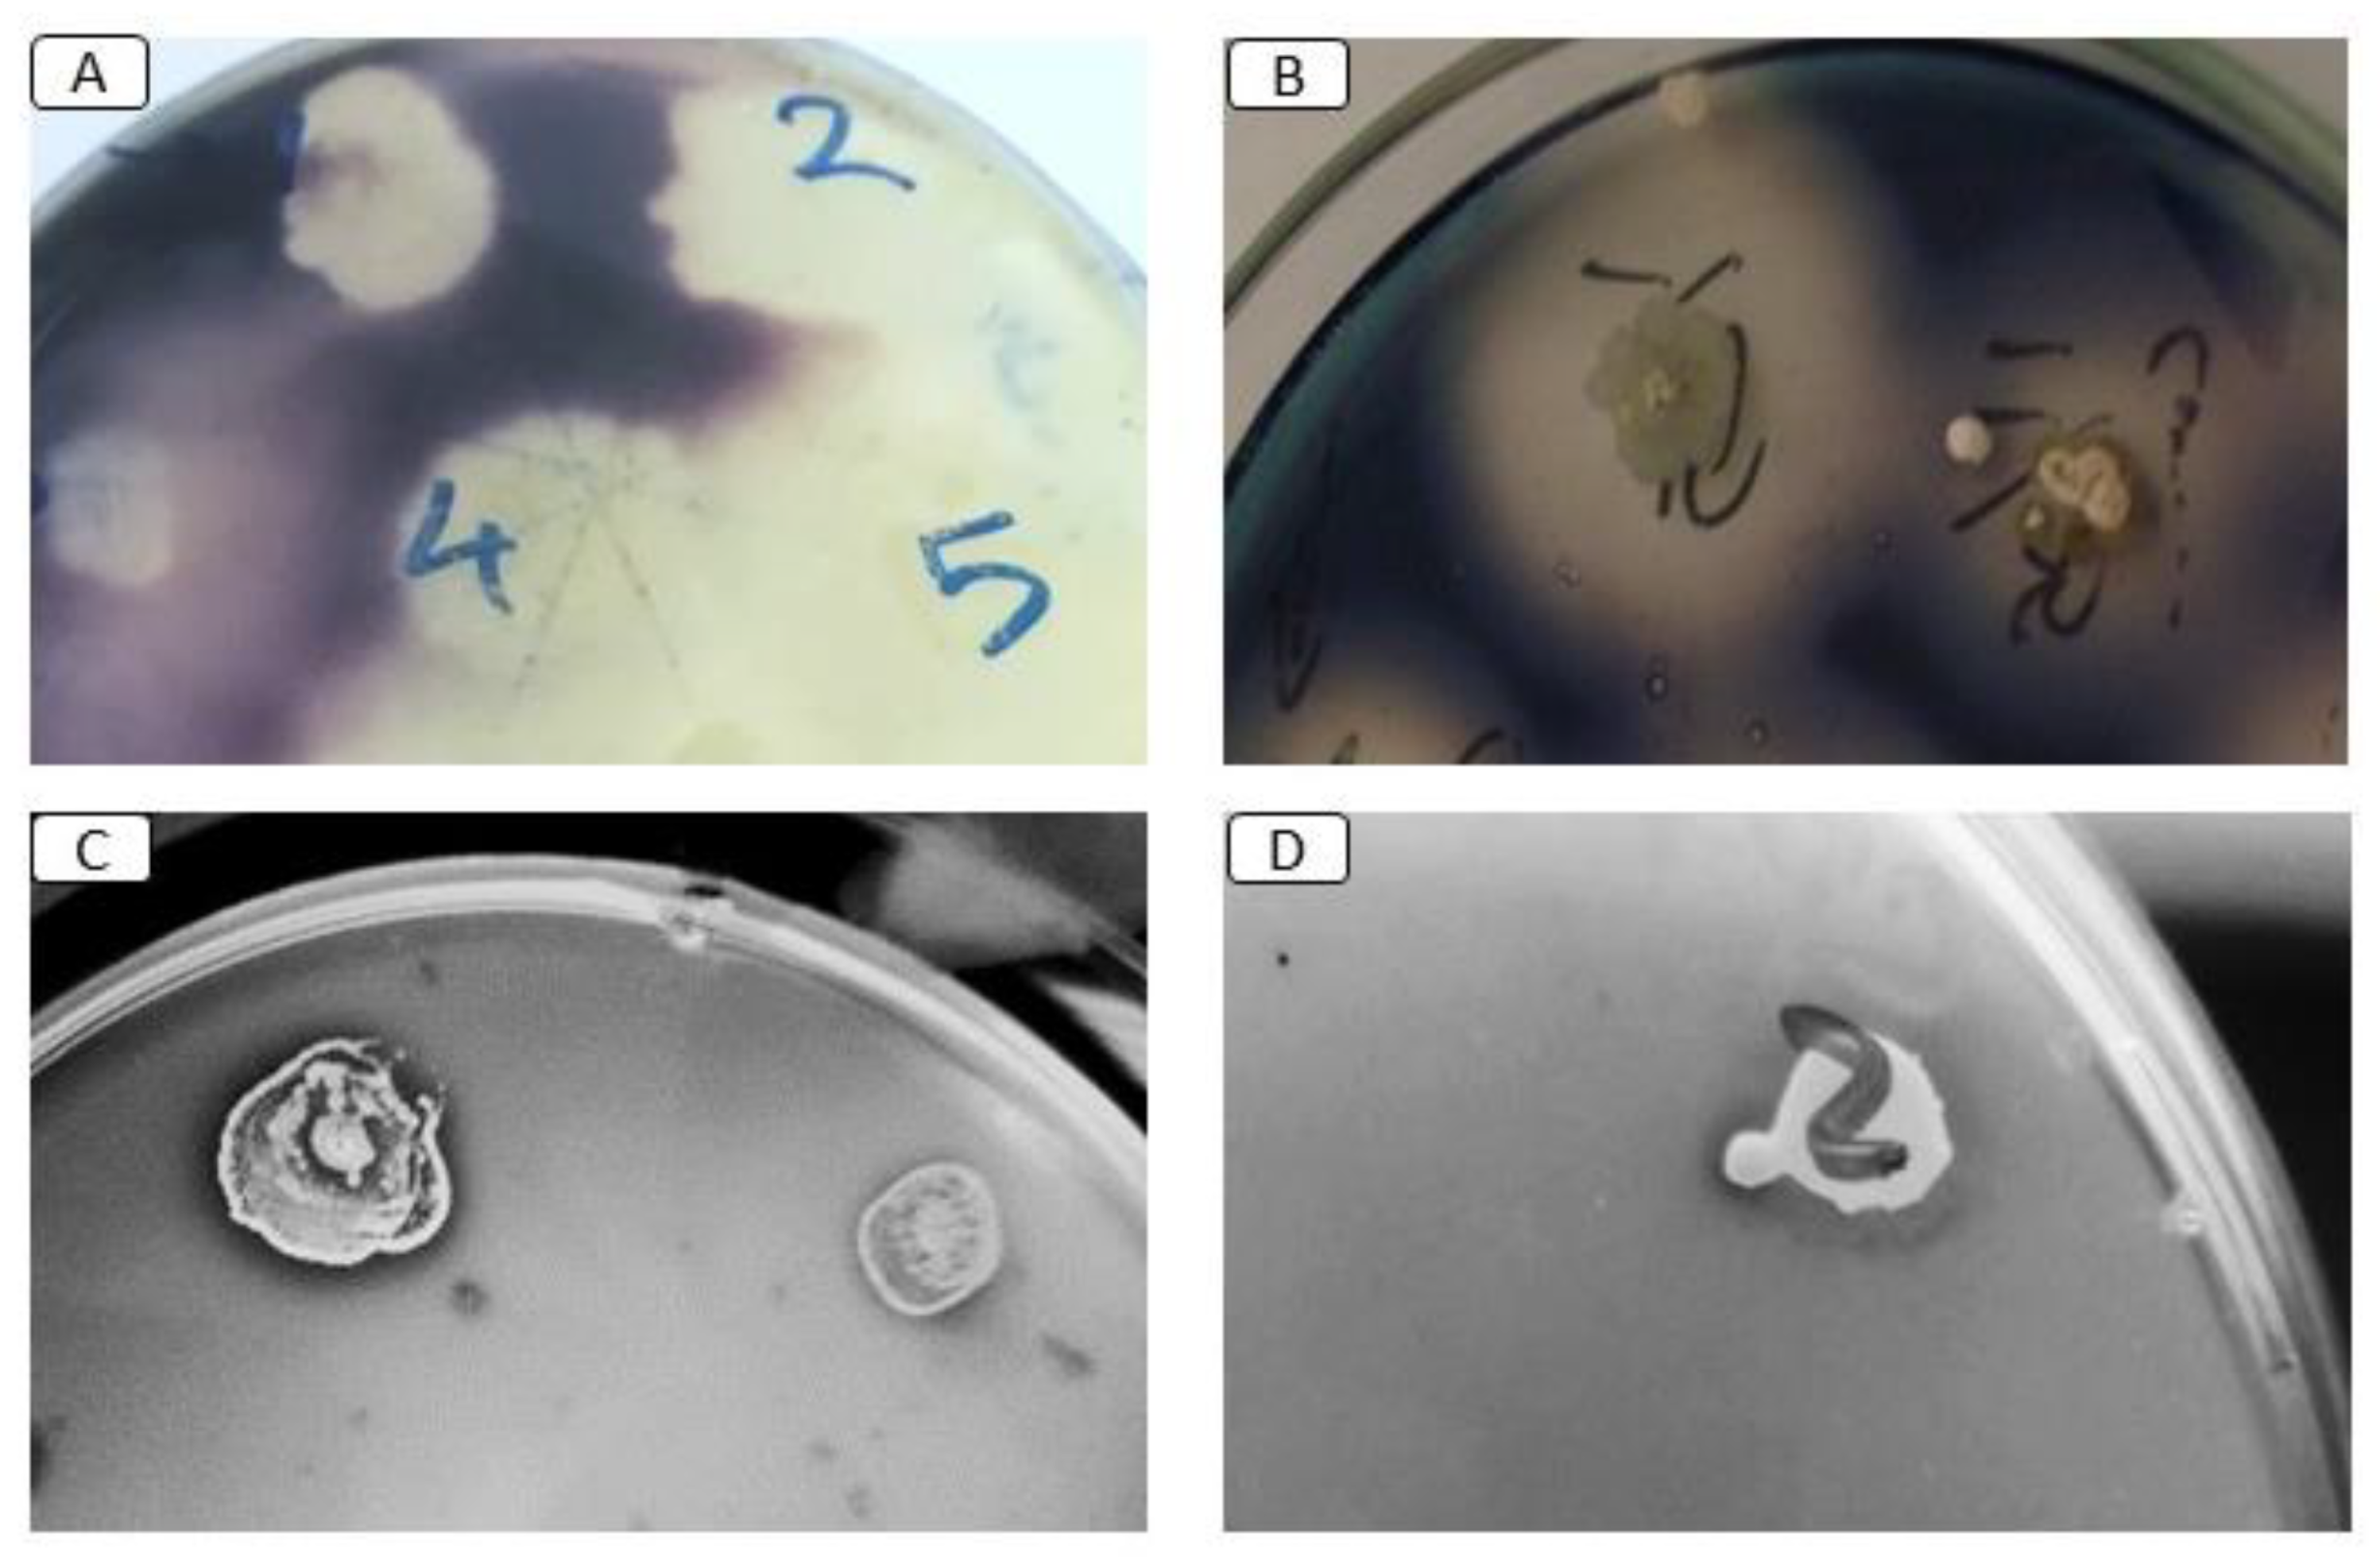
Microbiolres 15 00092 g003 Microbiolres 15 00092 g003

Exploring Gut Microbiota in Red Palm Weevil (Rhynchophorus ferrugineus): Effects on Pest Management, Pesticide Resistance, and Thermal Stress Tolerance
Abstract
1. Introduction
2. Materials and Methods
2.1. Insect Sampling and Rearing
2.2. Bacterial Isolation and Identification
2.3. Molecular Identification of Bacterial Isolates
2.3.1. Bacterial Genomic DNA Extraction
2.3.2. Bacterial 16S rRNA Amplification
2.4. Screening for the Production of Digestive Enzymes
2.5. Effect of Gut Microbiota on the Nutrition Metabolism of RPW Larvae In Vivo
2.6. Screening of Pesticide-Degrading Bacteria
2.7. Chlorpyrifos Biodegradation Assay In Vitro
2.8. Effect of Gut Microbiota on Chlorpyrifos Biodegradation of RPW Larvae In Vivo
2.9. Thermal Stress Treatment
2.9.1. Fitness Parameter Tests
2.9.2. Biochemical Analysis of Hemolymph (Hemolymph Index)
2.9.3. Antioxidant Assays
2.9.4. Gut Bacterial Isolation and Identification
2.10. Statistical Analysis
3. Results
3.1. Bacterial Isolation and Identification
3.2. Screening for the Production of Digestive Enzymes
3.3. Effect of Gut Microbiota on RPW Larvae’s Nutrient Metabolism In Vivo
3.4. Screening of Pesticide-Degrading Bacteria
3.5. Thermal Stress Treatment
4. Discussion
5. Conclusions
Author Contributions
Funding
Institutional Review Board Statement
Informed Consent Statement
Data Availability Statement
Conflicts of Interest
References
- Engel, P.; Moran, N.A. The Gut Microbiota of Insects—Diversity in Structure and Function. FEMS Microbiol. Rev. 2013, 37, 699–735. [Google Scholar] [CrossRef]
- Kikuchi, Y. Endosymbiotic Bacteria in Insects: Their Diversity and Culturability. Microbes Environ. 2009, 24, 195–204. [Google Scholar] [CrossRef]
- Masson, F.; Lemaitre, B. Growing Ungrowable Bacteria: Overview and Perspectives on Insect Symbiont Culturability. Microbiol. Mol. Biol. Rev. 2020, 84, 10–1128. [Google Scholar] [CrossRef] [PubMed]
- Li, G.; Zheng, X.; Zhu, Y.; Long, Y.; Xia, X. Bacillus Symbiont Drives Alterations in Intestinal Microbiota and Circulating Metabolites of Lepidopteran Host. Environ. Microbiol. 2022, 24, 4049–4064. [Google Scholar] [CrossRef]
- Ayyasamy, A.; Kempraj, V.; Pagadala Damodaram, K.J.; Jayanthi, K.; Damodaram, P. Endosymbiotic Bacteria Aid to Overcome Temperature Induced Stress in the Oriental Fruit Fly, Bactrocera dorsalis. Microb. Ecol. 2021, 82, 783–792. [Google Scholar] [CrossRef]
- Jaramillo, A.; Castañeda, L.E. Gut Microbiota of Drosophila subobscura Contributes to Its Heat Tolerance and Is Sensitive to Transient Thermal Stress. Front. Microbiol. 2021, 12, 654108. [Google Scholar] [CrossRef] [PubMed]
- Raza, M.F.; Wang, Y.; Cai, Z.; Bai, S.; Yao, Z.; Awan, A.; Zhang, Z.; Zheng, W.; Id, H.Z. Gut Microbiota Promotes Host Resistance to Low-Temperature Stress by Stimulating Its Arginine and Proline Metabolism Pathway in Adult Bactrocera dorsalis. PLoS Pathog. 2020, 16, e1008441. [Google Scholar] [CrossRef]
- Gil, R.; Latorre, A.; Moya, A. Bacterial Endosymbionts of Insects: Insights from Comparative Genomics. Environ. Microbiol. 2004, 6, 1109–1122. [Google Scholar] [CrossRef] [PubMed]
- Storelli, G.; Defaye, A.; Erkosar, B.; Hols, P.; Royet, J.; Leulier, F. Lactobacillus plantarum Promotes Drosophila Systemic Growth by Modulating Hormonal Signals through TOR-Dependent Nutrient Sensing. Cell Metab. 2011, 14, 403–414. [Google Scholar] [CrossRef]
- Wang, H.; Jin, L.; Zhang, H. Comparison of the Diversity of the Bacterial Communities in the Intestinal Tract of Adult Bactrocera dorsalis from Three Different Populations. J. Appl. Microbiol. 2011, 110, 1390–1401. [Google Scholar] [CrossRef] [PubMed]
- Jaffar, S.; Ahmad, S.; Lu, Y. Contribution of Insect Gut Microbiota and Their Associated Enzymes in Insect Physiology and Biodegradation of Pesticides. Front. Microbiol. 2022, 13, 979383. [Google Scholar] [CrossRef]
- Visôtto, L.E.; Oliveira, M.G.A.; Ribon, A.O.B.; Mares-Guia, T.R.; Guedes, R.N.C. Characterization and Identification of Proteolytic Bacteria from the Gut of the Velvetbean Caterpillar (Lepidoptera: Noctuidae). Environ. Entomol. 2009, 38, 1078–1085. [Google Scholar] [CrossRef] [PubMed]
- Wang, J.J.J.M.; Bai, J.; Zheng, F.Y.; Ling, Y.; Li, X.X.J.; Wang, J.J.J.M.; Zhi, Y.C.; Li, X.X.J. Diversity of the Gut Microbiome in Three Grasshopper Species Using 16S RRNA and Determination of Cellulose Digestibility. PeerJ 2020, 8, e10194. [Google Scholar] [CrossRef] [PubMed]
- Zheng, H.; Powell, J.E.; Steele, M.I.; Dietrich, C.; Moran, N.A. Honeybee Gut Microbiota Promotes Host Weight Gain via Bacterial Metabolism and Hormonal Signaling. Proc. Natl. Acad. Sci. USA 2017, 114, 4775–4780. [Google Scholar] [CrossRef]
- FAO. Current Situation of Red Palm Weevil in the NENA Region [Current Situation of Management Practices, Challenges/Weaknesses and Available Research and Technologies for Its Improvement]. 2017, pp. 29–31. Available online: http://Www.Fao.Org/3/a-Ms664e.Pdf (accessed on 25 April 2021).
- El-Shafie, A.F.H.; Faleiro, R.J. Red Palm Weevil Rhynchophorus ferrugineus (Coleoptera: Curculionidae): Global Invasion, Current Management Options, Challenges and Future Prospects. In Invasive Species—Introduction Pathways, Economic Impact, and Possible Management Options; El-Shafie, H., Ed.; Intechopen: London, UK, 2020; pp. 1–29. [Google Scholar]
- Al-Dosary, N.M.N.; Al-Dobai, S.; Faleiro, J.R. Review on the Management of Red Palm Weevil Rhynchophorus ferrugineus Olivier in Date Palm Phoenix Dactylifera L. Emir. J. Food Agric. 2016, 28, 34–44. [Google Scholar] [CrossRef]
- Rochat, D.; Dembilio, O.; Jaques, J.A.; Suma, P.; Alessandra, L.; Pergola;Hamidi, R.; Kontodimas, D.; Soroker, V. Rhynchophorus ferrugineus: Taxonomy, Distribution, Biology, and Life Cycle. In Handbook of Major Palm Pests; Soroker, V., Colazza, S., Eds.; Wiley-Blackwell: Chichester, UK, 2017; pp. 69–104. [Google Scholar]
- Kontodimas, D.; Soroker, V.; Pontikakos, C.; Suma, P.; Beaudoin-Ollivier, L.; Karamaouna, F.; Riolo, P. Visual Identification and Characterization of Rhynchophorus ferrugineus and Paysandisia Archon Infestation. In Handbook of Major Palm Pests: Biology and Management; Soroker, V., Colazza, S., Eds.; John Wiley & Sons: Chichester, UK, 2017; pp. 187–208. [Google Scholar]
- Abdel-Baky, N.F.; Aldeghairi, M.A.; Motawei, M.I.; Al-Shuraym, L.A.M.; Al-Nujiban, A.A.S.; Alharbi, M.T.M.; Rehan, M. Monitoring of Infestation Percentages of the Invasive Red Palm Weevil, Rhynchophorus ferrugineus (Coleoptera: Curculionidae), and Management Tactics: A Six-Year Study. Braz. J. Biol. 2022, 82, e263707. [Google Scholar] [CrossRef] [PubMed]
- Mazza, G.; Francardi, V.; Simoni, S.; Benvenuti, C.; Cervo, R.; Faleiro, J.R.; Llácer, E.; Longo, S.; Nannelli, R.; Tarasco, E.; et al. An Overview on the Natural Enemies of Rhynchophorus Palm Weevils, with Focus on R. ferrugineus. Biol. Control. 2014, 77, 83–92. [Google Scholar] [CrossRef]
- Peng, L.; Miao, Y.; Hou, Y. Demographic Comparison and Population Projection of Rhynchophorus ferrugineus (Coleoptera: Curculionidae) Reared on Sugarcane at Different Temperatures. Sci. Rep. 2016, 6, 31659. [Google Scholar] [CrossRef]
- Liu, Q.; Su, Z.; Liu, H.; Lu, S.; Ma, B.; Zhao, Y.; Hou, Y.; Shi, Z. The Effect of Gut Bacteria on the Physiology of Red Palm Weevil, Rhynchophorus ferrugineus Olivier and Their Potential for the Control of This Pest. Insects 2021, 12, 594. [Google Scholar] [CrossRef]
- Habineza, P.; Muhammad, A.; Ji, T.; Xiao, R.; Yin, X.; Hou, Y.; Shi, Z. The Promoting Effect of Gut Microbiota on Growth and Development of Red Palm Weevil, Rhynchophorus ferrugineus (Olivier) (Coleoptera: Dryophthoridae) by Modulating Its Nutritional Metabolism. Front. Microbiol. 2019, 10, 1212. [Google Scholar] [CrossRef]
- ElKraly, O.A.; Awad, M.; El-Saadany, H.M.; Hassanein, S.E.; Elrahman, T.A.; Elnagdy, S.M. Impact of Gut Microbiota Composition on Black Cutworm, Agrotis ipsilon (Hufnagel) Metabolic Indices and Pesticide Degradation. Anim. Microbiome 2023, 5, 44. [Google Scholar] [CrossRef] [PubMed]
- Jia, S.; Zhang, X.; Zhang, G.; Yin, A.; Zhang, S.; Li, F.; Wang, L.; Zhao, D.; Yun, Q.; Wang, J.; et al. Seasonally Variable Intestinal Metagenomes of the Red Palm Weevil (Rhynchophorus ferrugineus). Environ. Microbiol. 2013, 15, 3020–3029. [Google Scholar] [CrossRef] [PubMed]
- Shi, W.; Xie, S.; Chen, X.; Sun, S.; Zhou, X.; Liu, L.; Gao, P.; Kyrpides, N.C.; No, E.G.; Yuan, J.S. Comparative Genomic Analysis of the Endosymbionts of Herbivorous Insects Reveals Eco-Environmental Adaptations: Biotechnology Applications. PLoS Genet. 2013, 9, e1003131. [Google Scholar] [CrossRef]
- Muhammad, A.; Fang, Y.; Hou, Y.; Shi, Z. The Gut Entomotype of Red Palm Weevil Rhynchophorus ferrugineus Olivier (Coleoptera: Dryophthoridae) and Their Effect on Host Nutrition Metabolism. Front. Microbiol. 2017, 8, 2291. [Google Scholar] [CrossRef] [PubMed]
- Ceja-Navarro, J.A.; Karaoz, U.; Bill, M.; Hao, Z.; White, R.A.; Arellano, A.; Ramanculova, L.; Filley, T.R.; Berry, T.D.; Conrad, M.E.; et al. Gut Anatomical Properties and Microbial Functional Assembly Promote Lignocellulose Deconstruction and Colony Subsistence of a Wood-Feeding Beetle. Nat. Microbiol. 2019, 4, 864–875. [Google Scholar] [CrossRef] [PubMed]
- Jing, T.; Qi, F.; Wang, Z. Most Dominant Roles of Insect Gut Bacteria: Digestion, Detoxification, or Essential Nutrient Provision? Microbiome 2020, 8, 38. [Google Scholar] [CrossRef] [PubMed]
- Valzano, M.; Achille, G.; Burzacca, F.; Ricci, I.; Damiani, C.; Scuppa, P.; Favia, G. Deciphering Microbiota Associated to Rhynchophorus ferrugineus in Italian Samples: A Preliminary Study. J. Entomol. Acarol. Res. 2012, 44, 85–89. [Google Scholar] [CrossRef]
- Tagliavia, M.; Messina, E.; Manachini, B.; Cappello, S.; Quatrini, P. The Gut Microbiota of Larvae of Rhynchophorus ferrugineus Oliver (Coleoptera: Curculionidae). BMC Microbiol. 2014, 14, 136. [Google Scholar] [CrossRef] [PubMed]
- Dawadi, B.; Wang, X.; Xiao, R.; Muhammad, A.; Hou, Y.; Shi, Z. PGRP-LB Homolog Acts as a Negative Modulator of Immunity in Maintaining the Gut-Microbe Symbiosis of Red Palm Weevil, Rhynchophorus ferrugineus Olivier. Dev. Comp. Immunol. 2018, 86, 65–77. [Google Scholar] [CrossRef]
- Gracy, R.G.; Malathi, V.M.; Jalali, S.K.; Jose, V.L.; Thulasi, A. Variation in Larval Gut Bacteria between Insecticide-Resistant and -Susceptible Populations of Helicoverpa armigera (Hübner) (Lepidoptera: Noctuidae). Phytoparasitica 2016, 44, 477–490. [Google Scholar] [CrossRef]
- Cheng, D.; Guo, Z.; Riegler, M.; Xi, Z.; Liang, G.; Xu, Y. Gut Symbiont Enhances Insecticide Resistance in a Significant Pest, the Oriental Fruit Fly Bactrocera dorsalis (Hendel). Microbiome 2017, 5, 1–12. [Google Scholar] [CrossRef] [PubMed]
- Xia, X.; Sun, B.; Gurr, G.G.M.G.; Vasseur, L.; Xue, M.; You, M.; Yu, Z.; Newcombe, G.; Xu, Y.; You, M.; et al. Gut Microbiota Mediate Insecticide Resistance in the Diamondback Moth, Plutella xylostella (L.). Front. Microbiol. 2018, 9, 25. [Google Scholar] [CrossRef]
- Gressel, J. Microbiome Facilitated Pest Resistance: Potential Problems and Uses. Pest Manag. Sci. 2018, 74, 511–515. [Google Scholar] [CrossRef] [PubMed]
- Chen, B.; Zhang, N.; Xie, S.; Zhang, X.; He, J.; Muhammad, A.; Sun, C.; Lu, X.; Shao, Y.; Sunb, C.; et al. Gut Bacteria of the Silkworm Bombyx mori Facilitate Host Resistance against the Toxic Effects of Organophosphate Insecticides. Environ. Int. 2020, 143, 105886. [Google Scholar] [CrossRef]
- Gomes, A.F.F.; Omoto, C.; Cônsoli, F.L. Gut Bacteria of Field-Collected Larvae of Spodoptera frugiperda Undergo Selection and Are More Diverse and Active in Metabolizing Multiple Insecticides than Laboratory-Selected Resistant Strains. J. Pest Sci. 2020, 93, 833–851. [Google Scholar] [CrossRef]
- Yang, C.; Liu, N.; Guo, X.; Qiao, C. Cloning of Mpd Gene from a Chlorpyrifos-Degrading Bacterium and Use of This Strain in Bioremediation of Contaminated Soil. FEMS Microbiol. Lett. 2006, 265, 118–125. [Google Scholar] [CrossRef] [PubMed]
- Li, X.; He, J.; Li, S. Isolation of a Chlorpyrifos-Degrading Bacterium, Sphingomonas Sp. Strain Dsp-2, and Cloning of the Mpd Gene. Res. Microbiol. 2007, 158, 143–149. [Google Scholar] [CrossRef]
- Kikuchi, Y.; Hayatsu, M.; Hosokawa, T.; Nagayama, A.; Tago, K.; Fukatsu, T. Symbiont-Mediated Insecticide Resistance. Proc. Natl. Acad. Sci. USA 2012, 109, 8618–8622. [Google Scholar] [CrossRef]
- Mozib, M.E.; El-Shafie, H.A. Effect of Red Palm Weevil, Rhynchophorus ferrugineus (Olivier) Infestation on Temperature Profiles of Date Palm Tree. J. Entomol. Nematol. 2013, 5, 77–83. [Google Scholar] [CrossRef][Green Version]
- Salama, H.S.; Hamdy, M.K.; El-Din, M.M. The Thermal Constant for Timing the Emergence of the Red Palm Weevil, Rhynchophorus ferrugineus (Oliv.) (Coleoptera, Curculionidae). Anz. Fur Schadlingskunde 2002, 75, 26–29. [Google Scholar] [CrossRef]
- Dembilio, Ó.; Jacas, J.A. Basic Bio-Ecological Parameters of the Invasive Red Palm Weevil, Rhynchophorus ferrugineus (Coleoptera: Curculionidae), in Phoenix canariensis under Mediterranean Climate. Bull. Entomol. Res. 2011, 101, 153–163. [Google Scholar] [CrossRef] [PubMed]
- Martín, M.M.; García, T.C. Manejo de La Cría Del Picudo Rojo de La Palmera, Rhynchophorus ferrugineus (Olivier, 1790) (Coleoptera, Dryophthoridae), En Dieta Artificial y Efectos En Su Biometría y Biología. Bol. Sanid. Veg. Plagas 2006, 32, 631–642. [Google Scholar]
- Mahmud, A.I.; Viez, E.R.A.; Bruxelles, U.L.D.; Brussel, V.U.; Degli, U.; Firenze, S.; Terengganu, K. Red Palm Weevil (Rhynchophorus ferrugineus Olivier, 1790): Threat of Palms. J. Biol. Sci. 2015, 15, 56–67. [Google Scholar] [CrossRef]
- Sukirno, S.; Tufail, M.; Rasool, K.G.; Aldawood, A.S. Palm Weevil Diversity in Indonesia: Description of Phenotypic Variability in Asiatic Palm Weevil, Rhynchophorus vulneratus (Coleoptera: Curculionidae). J. Entomol. Res. Soc. 2018, 20, 1–22. [Google Scholar]
- Kaakeh, W.; Abou-Nour, M.M.; Khamis, A.A. Mass Rearing of the Red Palm Weevil, Rhynchophorus ferrugineus Oliv., on Sugarcane and Artificial Diets for Laboratory Studies: Illustration of Methodology. In Proceedings of the Second International Conference on Date Palm, Al-Ain, United Arab Emirates, 25–27 March 2001; pp. 344–357. [Google Scholar]
- Food and Agriculture Organization of the United Nations (FAO). Red Palm Weevil: Guidelines on Management Practices; FAO: Rome, Italy, 2020. [Google Scholar]
- Regev, A.; Keller, M.; Strizhov, N.; Sneh, B.; Prudovsky, E.; Chet, I.; Ginzberg, I.; Koncz-Kalman, Z.; Koncz, C.; Schell, J.; et al. Synergistic Activity of a Bacillus thuringiensis δ-Endotoxin and a Bacterial Endochitinase against Spodoptera littoralis Larvae. Appl. Environ. Microbiol. 1996, 62, 3581–3586. [Google Scholar] [CrossRef] [PubMed]
- Muhammad, A.; Habineza, P.; Hou, Y.; Shi, Z. Preparation of Red Palm Weevil Rhynchophorus ferrugineus (Olivier) (Coleoptera: Dryophthoridae) Germ-Free Larvae for Host-Gut Microbes Interaction Studies. Bio Protoc. 2019, 9, e3456. [Google Scholar] [CrossRef]
- Rojas-Jiménez, K.; Hernández, M. Isolation of Fungi and Bacteria Associated with the Guts of Tropical Wood-Feeding Coleoptera and Determination of Their Lignocellulolytic Activities. Int. J. Microbiol. 2015, 2015, 285018. [Google Scholar] [CrossRef]
- Indiragandhi, P.; Anandham, R.; Madhaiyan, M.; Poonguzhali, S.; Kim, G.H.; Saravanan, V.S.; Sa, T. Cultivable Bacteria Associated with Larval Gut of Prothiofos-Resistant, Prothiofos-Susceptible and Field-Caught Populations of Diamondback Moth, Plutella xylostella and Their Potential for, Antagonism towards Entomopathogenic Fungi and Host Insect Nutriti. J. Appl. Microbiol. 2007, 103, 2664–2675. [Google Scholar] [CrossRef]
- Suzuki, M.T.; Taylor, L.T.; DeLong, E.F. Quantitative Analysis of Small-Subunit RRNA Genes in Mixed Microbial Populations via 5′-Nuclease Assays. Appl. Environ. Microbiol. 2000, 66, 4605–4614. [Google Scholar] [CrossRef]
- Shigeno, Y.; Toyama, M.; Nakamura, M.; Niimi, K.; Takahashi, E.; Benno, Y. Comparison of Gut Microbiota Composition between Laboratory-Bred Marmosets (Callithrix jacchus) with Chronic Diarrhea and Healthy Animals Using Terminal Restriction Fragment Length Polymorphism Analysis. Microbiol. Immunol. 2018, 62, 702–710. [Google Scholar] [CrossRef]
- Abdelmoneim, T.K.; Mohamed, M.S.M.; Abdelhamid, I.A.; Wahdan, S.F.M.; Atia, M.A.M. Development of Rapid and Precise Approach for Quantification of Bacterial Taxa Correlated with Soil Health. Front. Microbiol. 2023, 13, 1095045. [Google Scholar] [CrossRef] [PubMed]
- Zhang, Z.; Schwartz, S.; Wagner, L.; Miller, W. A Greedy Algorithm for Aligning DNA Sequences. J. Comput. Biol. 2000, 7, 203–214. [Google Scholar] [CrossRef] [PubMed]
- Madeira, F.; Pearce, M.; Tivey, A.R.N.; Basutkar, P.; Lee, J.; Edbali, O.; Madhusoodanan, N.; Kolesnikov, A.; Lopez, R. Search and Sequence Analysis Tools Services from EMBL-EBI in 2022. Nucleic Acids Res. 2022, 50, W276–W279. [Google Scholar] [CrossRef] [PubMed]
- Huerta-Cepas, J.; Serra, F.; Bork, P. ETE 3: Reconstruction, Analysis, and Visualization of Phylogenomic Data. Mol. Biol. Evol. 2016, 33, 1635–1638. [Google Scholar] [CrossRef]
- Nguyen, L.; Schmidt, H.; von Haeseler, A.; Minh, B. IQ-TREE: A Fast and Effective Stochastic Algorithm for Estimating Maximum-Likelihood Phylogenies. Mol. Biol. Evol. 2015, 32, 268–274. [Google Scholar] [CrossRef] [PubMed]
- Berg, B.; Hofsten, B.V.; Pettersson, G. Growth and Cellulase Formation by Cellvibrio fulvus. J. Appl. Bacteriol. 1972, 35, 201–214. [Google Scholar] [CrossRef] [PubMed]
- Anand, A.A.P.; Vennison, S.J.; Sankar, S.G.; Prabhu, D.I.G.; Vasan, P.T.; Raghuraman, T.; Geoffrey, C.J.; Vendan, S.E. Isolation and Characterization of Bacteria from the Gut of Bombyx mori That Degrade Cellulose, Xylan, Pectin and Starch and Their Impact on Digestion. J. Insect Sci. 2010, 10, 107. [Google Scholar] [CrossRef] [PubMed]
- De Veras, B.O.; Dos Santos, Y.Q.; Diniz, K.M.; Carelli, G.S.C.; Dos Santos, E.A. Screening of Protease, Cellulase, Amylase and Xylanase from the Salt-Tolerant and Thermostable Marine Bacillus subtilis Strain Sr60 [Version 1; Peer Review: 1 Approved with Reservations]. F1000Res 2018, 7, 1704. [Google Scholar] [CrossRef]
- Rehman, U.H.; Naveed, N.; Aman, A.; Asif, M.; Hameed, A.; Ali, S.; Qader, U. Morphological and Molecular Based Identification of Pectinase Producing Bacillus licheniformis from Rotten Vegetable. J. Genet. Eng. Biotechnol. 2015, 13, 139–144. [Google Scholar] [CrossRef]
- Sierra, G. A Simple Method for the Detection of Lipolytic Activity of Micro-Organisms and Some Observations on the Influence of the Contact between Cells and Fatty Substrates. Antonie Van Leeuwenhoek 1957, 23, 15–22. [Google Scholar] [CrossRef]
- Willerding, L.; Oliveira, L.A.D.; Moreira, F.W.; Germano, M.G.; Chagas, A.F., Jr. Lipase Activity among Bacteria Isolated from Amazonian Soils. Enzym. Res. 2011, 2011, 1–5. [Google Scholar] [CrossRef]
- Kumar, D.; Kumar, L.; Nagar, S.; Raina, C.; Parshad, R.; Gupta, V.K. Screening, Isolation and Production of Lipase/Esterase Producing Bacillus sp. Strain DVL2 and Its Potential Evaluation in Esterification and Resolution Reactions. Arch. Appl. Sci. Res. 2012, 4, 1763–1770. [Google Scholar]
- Chu, C.C.; Spencer, J.L.; Curzi, M.J.; Zavala, J.A.; Seufferheld, M.J. Gut Bacteria Facilitate Adaptation to Crop Rotation in the Western Corn Rootworm. Proc. Natl. Acad. Sci. USA 2013, 110, 11917–11922. [Google Scholar] [CrossRef] [PubMed]
- Xia, X.; Lan, B.; Tao, X.; Lin, J.; You, M. Characterization of Spodoptera litura Gut Bacteria and Their Role in Feeding and Growth of the Host. Front. Microbiol. 2020, 11, 1492. [Google Scholar] [CrossRef]
- Anastassiades, M.; Lehotay, S.J.; Štajnbaher, D.; Schenck, F.J. Fast and Easy Multiresidue Method Employing Acetonitrile Extraction/Partitioning and “Dispersive Solidphase Extraction” for the Determination of Pesticide Residues in Produce. J. AOAC Int. 2003, 86, 412–431. [Google Scholar] [CrossRef] [PubMed]
- Ibrahima, M.A.; Belal, M.H.; Abdallah, I.S.; El-Sawi, S.A.M. Monitoring and Risk Assessment of Pesticide Residues in Some Locally Produced Vegetables and Fruits. Egypt. J. Chem. 2022, 65, 429–439. [Google Scholar] [CrossRef]
- Salama, M.; Barakat, D.; Ibrahim, E.-D. Effectiveness and Persistence of Some Synthetic Insecticides and Their Nanoformulation Against Whitefly (Bemisia tabaci) and Aphids (Aphis craccivora) on Fennel Plants and Soil. Egypt. J. Chem. 2022, 66, 235–246. [Google Scholar] [CrossRef]
- Shawir, M.S.; Abbassy, M.A.; Salem, Y.M. Laboratory Evaluation of Some Insecticides against Larval and Adult Stages of Red Palm Weevil’s Rhynchophorus ferrugineus (Olivier). Alex. Sci. Exch. J. Int. Q. J. Sci. Agric. Environ. 2014, 35, 75–79. [Google Scholar] [CrossRef]
- Ahmed, F.; El-Sobki, A. Biochemical and Histological Responses of Red Palm Weevil, Rhynchophorus ferrugineus Exposed to Sub-Lethal Levels of Different Insecticide Classes. Egypt. Acad. J. Biol. Sci. F Toxicol. Pest Control. 2021, 13, 293–308. [Google Scholar] [CrossRef]
- De Almeida, L.G.; De Moraes, L.A.B.; Trigo, J.R.; Omoto, C.; Cônsoli, F.L. The Gut Microbiota of Insecticide-Resistant Insects Houses Insecticide-Degrading Bacteria: A Potential Source for Biotechnological Exploitation. PLoS ONE 2017, 12, e0174754. [Google Scholar] [CrossRef]
- Chen, H.; Zhang, M.; Hochstrasser, M. The Biochemistry of Cytoplasmic Incompatibility Caused by Endosymbiotic Bacteria. Genes 2020, 11, 852. [Google Scholar] [CrossRef] [PubMed]
- León-Quinto, T.; Fimia, A.; Madrigal, R.; Serna, A. Morphological Response of the Red Palm Weevil, Rhynchophorus ferrugineus, to a Transient Low Temperature Analyzed by Computer Tomography and Holographic Microscopy. J. Therm. Biol. 2020, 94, 102748. [Google Scholar] [CrossRef] [PubMed]
- Awad, M.; Ibrahim, E.D.S.; Osman, E.I.; Elmenofy, W.H.; Mahmoud, A.W.M.; Atia, M.A.M.; Moustafa, M.A.M. Nano-Insecticides against the Black Cutworm Agrotis ipsilon (Lepidoptera: Noctuidae): Toxicity, Development, Enzyme Activity, and DNA Mutagenicity. PLoS ONE 2022, 17, e0254285. [Google Scholar] [CrossRef] [PubMed]
- Moustafa, M.A.M.; Awad, M.; Amer, A.; Hassan, N.N.; Ibrahim, E.D.S.; Ali, H.M.; Akrami, M.; Salem, M.Z.M. Insecticidal Activity of Lemongrass Essential Oil as an Eco-Friendly Agent against the Black Cutworm Agrotis ipsilon (Lepidoptera: Noctuidae). Insects 2021, 12, 737. [Google Scholar] [CrossRef] [PubMed]
- Zhang, G.; Liu, H.; Wang, J.; Wang, Z. Effects of Thermal Stress on Lipid Peroxidation and Antioxidant Enzyme Activities of the Predatory Mite, Neoseiulus cucumeris (Acari: Phytoseiidae). Exp. Appl. Acarol. 2014, 64, 73–85. [Google Scholar] [CrossRef] [PubMed]
- Kandler, O.; Weiss, N.; Sneath, P.H.A.; Mair, N.S.; Sharpe, M.E.; Holt, J.G. Bergey’s Manual of Systematic Bacteriology; Williams Williams Baltim: Philadelphia, PA, USA, 1986; Volume 1, pp. 1208–1234. [Google Scholar]
- Palleroni, N.J. Gram-Negative Aerobic Rods and Cocci, Family I. Pseudomonadaceae. Bergey’s Man. Syst. Bacteriol. 1984, 1, 140–219. [Google Scholar]
- Awad, M.; Sharaf, A.; Elrahman, T.A.; El-Saadany, H.M.; ElKraly, O.A.; Elnagdy, S.M.; Abd, T.; Hassan, E.; El, M.; Elrahman, T.A.; et al. The First Report for the Presence of Spiroplasma and Rickettsia in Red Palm Weevil Rhynchophorus ferrugineus (Coleoptera: Curculionidae) in Egypt. Acta Parasitol. 2021, 66, 593–604. [Google Scholar] [CrossRef] [PubMed]
- Khiyami, M.; Alyamani, E. Aerobic and Facultative Anaerobic Bacteria from Gut of Red Palm Weevil (Rhynchophorus ferrugineus). Afr. J. Biotechnol. 2008, 7, 1432–1437. [Google Scholar]
- Mohamed, A.M.A.; Farooq, M.; Pathak, M.R. Identification and Characterization of Bacterial Community Associated with the Chewed Feeding Waste of Red Palm Weevil in Infested Date Palm Trees. Adv. Biosci. Biotechnol. 2020, 11, 80–93. [Google Scholar] [CrossRef]
- Butera, G.; Ferraro, C.; Colazza, S.; Alonzo, G.; Quatrini, P. The Culturable Bacterial Community of Frass Produced by Larvae of Rhynchophorus ferrugineus Olivier (Coleoptera: Curculionidae) in the Canary Island Date Palm. Lett. Appl. Microbiol. 2012, 54, 530–536. [Google Scholar] [CrossRef]
- Montagna, M.; Chouaia, B.; Mazza, G.; Prosdocimi, E.M.; Crotti, E.; Mereghetti, V.; Vacchini, V.; Giorgi, A.; De Biase, A.; Longo, S.; et al. Effects of the Diet on the Microbiota of the Red Palm Weevil (Coleoptera: Dryophthoridae). PLoS ONE 2015, 10, e0117439. [Google Scholar] [CrossRef]
- Osman, B.M.A.; Magdy, M.; Elsharabasy, S.F.; Rashed, M.A.; Ibrahim, S.A. Molecular Analysis of Gut Bacterial Endosymbionts Diversity in Red Palm Weevil Larvae, Rhynchophorus ferrugineus (Coleoptera; Curculionidae). Arab Univ. J. Agric. Sci. 2018, 26, 1213–1221. [Google Scholar] [CrossRef]
- Zhang, N.; He, J.; Shen, X.; Sun, C.; Muhammad, A.; Shao, Y. Contribution of Sample Processing to Gut Microbiome Analysis in the Model Lepidoptera, Silkworm Bombyx mori. Comput. Struct. Biotechnol. J. 2021, 19, 4658–4668. [Google Scholar] [CrossRef]
- Chen, B.; Yu, T.; Xie, S.; Du, K.; Liang, X.; Lan, Y.; Sun, C.; Lu, X.; Shao, Y. Data Descriptor: Comparative Shotgun Metagenomic Data of the Silkworm Bombyx mori Gut Microbiome. Sci. Data 2018, 5, 180285. [Google Scholar] [CrossRef] [PubMed]
- Ramya, S.L.; Venkatesan, T.; Srinivasa Murthy, K.S.; Jalali, S.K.; Verghese, A. Detection of Carboxylesterase and Esterase Activity in Culturable Gut Bacterial Flora Isolated from Diamondback Moth, Plutella xylostella (Linnaeus), from India and Its Possible Role in Indoxacarb Degradation. Braz. J. Microbiol. 2016, 47, 327–336. [Google Scholar] [CrossRef] [PubMed]
- Gandotra, S.; Bhuyan, P.M.; Gogoi, D.K.; Kumar, A.; Subramanian, S. Screening of Nutritionally Important Gut Bacteria from the Lepidopteran Insects Through Qualitative Enzyme Assays. Proc. Natl. Acad. Sci. India Sect. B Biol. Sci. 2018, 88, 329–337. [Google Scholar] [CrossRef]
- Shil, R.K.; Mojumder, S.; Sadida, F.F.; Uddin, M.; Sikdar, D. Isolation and Identification of Cellulolytic Bacteria from the Gut of Three Phytophagus Insect Species. Braz. Arch. Biol. Technol. 2014, 57, 927–932. [Google Scholar] [CrossRef]
- Ghodake, G.S.; Kalme, S.D.; Jadhav, J.P.; Govindwar, S.P. Purification and Partial Characterization of Lignin Peroxidase from Acinetobacter calcoaceticus NCIM 2890 and Its Application in Decolorization of Textile Dyes. Appl. Biochem. Biotechnol. 2009, 152, 6–14. [Google Scholar] [CrossRef] [PubMed]
- Rizzi, A.; Crotti, E.; Borruso, L.; Jucker, C.; Lupi, D.; Colombo, M.; Daffonchio, D. Characterization of the Bacterial Community Associated with Larvae and Adults of Anoplophora chinensis Collected in Italy by Culture and Culture-Independent Methods. Biomed. Res. Int. 2013, 2013, 420287. [Google Scholar] [CrossRef]
- Yang, J.; Zhao, J.; Wang, B.; Yu, Z. Unraveling Aerobic Cultivable Cellulolytic Microorganisms within the Gastrointestinal Tract of Sheep (Ovis aries) and Their Evaluation for Cellulose Biodegradation. Can. J. Microbiol. 2021, 68, 237–248. [Google Scholar] [CrossRef]
- Takasuka, T.E.; Book, A.J.; Lewin, G.R.; Currie, C.R.; Fox, B.G. Aerobic Deconstruction of Cellulosic Biomass by an Insect-Associated Streptomyces. Sci. Rep. 2013, 3, srep01030. [Google Scholar] [CrossRef] [PubMed]
- Castañeda-Cisneros, Y.E.; Mercado-Flores, Y.; Anducho-Reyes, M.A.; Álvarez-Cervantes, J.; Ponce-Lira, B.; Evangelista-Martínez, Z.; Téllez-Jurado, A. Isolation and Selection of Streptomyces Species from Semi-arid Agricultural Soils and Their Potential as Producers of Xylanases and Cellulases. Curr. Microbiol. 2020, 77, 3472. [Google Scholar] [CrossRef] [PubMed]
- Saini, A.; Aggarwal, N.K.; Sharma, A.; Yadav, A.; Ventorino, V.; Ionata, E.; Birolo, L.; Montella, S.; Marcolongo, L.; de Chiaro, A.; et al. Actinomycetes: A Source of Lignocellulolytic Enzymes. Enzym. Res. 2015, 2015, 279381. [Google Scholar] [CrossRef]
- Ventorino, V.; Ionata, E.; Birolo, L.; Montella, S.; Marcolongo, L.; de Chiaro, A.; Espresso, F.; Faraco, V.; Pepe, O. Lignocellulose-Adapted Endo-Cellulase Producing Streptomyces Strains for Bioconversion of Cellulose-Based Materials. Front. Microbiol. 2016, 7, 2061. [Google Scholar] [CrossRef]
- Korayem, A.S.; Abdelhafez, A.A.; Zaki, M.M.; Saleh, E.A. Optimization of Biosurfactant Production by Streptomyces Isolated from Egyptian Arid Soil Using Plackett–Burman Design. Ann. Agric. Sci. 2015, 60, 209–217. [Google Scholar] [CrossRef]
- Ghorbel, S.; Kammoun, M.; Soltana, H.; Nasri, M.; Hmidet, N. Streptomyces flavogriseus HS1: Isolation and Characterization of Extracellular Proteases and Their Compatibility with Laundry Detergents. Biomed. Res. Int. 2014, 2014, 345980. [Google Scholar] [CrossRef] [PubMed]
- Hassan, B.; Siddiqui, J.A.; Xu, Y. Vertically Transmitted Gut Bacteria and Nutrition Influence the Immunity and Fitness of Bactrocera dorsalis Larvae. Front. Microbiol. 2020, 11, 596352. [Google Scholar] [CrossRef]
- Wong, A.C.N.; Dobson, A.J.; Douglas, A.E. Gut Microbiota Dictates the Metabolic Response of Drosophila to Diet. J. Exp. Biol. 2014, 217, 1894–1901. [Google Scholar] [CrossRef]
- Douglas, A.E. Multiorganismal Insects: Diversity and Function of Resident Microorganisms. Annu. Rev. Entomol. 2015, 60, 17–34. [Google Scholar] [CrossRef]
- Rizou, E.; Kalogiouri, N.; Bisba, M.; Papadimitriou, A.; Kyrila, G.; Lazou, A. Amelioration of Growth, Nutritional Value, and Microbial Load of Tenebrio molitor (Coleoptera: Tenebrionidae ) through Probiotic Supplemented Feed. Eur. Food Res. Technol. 2022, 248, 727–739. [Google Scholar] [CrossRef]
- Singh, B.K.; Walker, A.; Morgan, J.A.W.; Wright, D.J. Biodegradation of Chlorpyrifos by Enterobacter Strain B-14 and Its Use in Bioremediation of Contaminated Soils. Appl. Environ. Microbiol. 2004, 70, 4855–4863. [Google Scholar] [CrossRef] [PubMed]
- Itoh, H.; Tago, K.; Hayatsu, M.; Kikuchi, Y. Detoxifying Symbiosis: Microbe-Mediated Detoxification of Phytotoxins and Pesticides in Insects. Nat. Prod. Rep. 2018, 35, 434–454. [Google Scholar] [CrossRef] [PubMed]
- Siddiqui, J.A.; Khan, M.M.; Bamisile, B.S.; Hafeez, M.; Qasim, M.; Rasheed, M.T.; Rasheed, M.A.; Ahmad, S.; Shahid, M.I.; Xu, Y. Role of Insect Gut Microbiota in Pesticide Degradation: A Review. Front. Microbiol. 2022, 13, 870462. [Google Scholar] [CrossRef] [PubMed]
- Akbar, S.; Sultan, S. Soil Bacteria Showing a Potential of Chlorpyrifos Degradation and Plant Growth Enhancement. Braz. J. Microbiol. 2016, 47, 563–570. [Google Scholar] [CrossRef] [PubMed]
- Pino, N.; Peñuela, G. Simultaneous Degradation of the Pesticides Methyl Parathion and Chlorpyrifos by an Isolated Bacterial Consortium from a Contaminated Site. Int. Biodeterior. Biodegrad. 2011, 65, 827–831. [Google Scholar] [CrossRef]
- Mallick, K.; Bharati, K.; Banerji, A.; Shakil, N.A.; Sethunathan, N. Bacterial Degradation of Chlorpyrifos in Pure Cultures and in Soil. Bull. Environ. Contam. Toxicol. 1999, 62, 48–54. [Google Scholar] [CrossRef]
- El-Helow, E.R.; Badawy, M.E.I.; Mabrouk, M.E.M.; Mohamed, E.A.H.; El-Beshlawy, Y.M. Biodegradation of Chlorpyrifos by a Newly Isolated Bacillus subtilis Strain, Y242. Bioremediat J. 2013, 17, 113–123. [Google Scholar] [CrossRef]
- Kim, H.; Kim, D.U.; Lee, H.; Yun, J.; Ka, J.O. Syntrophic Biodegradation of Propoxur by Pseudaminobacter sp. SP1a and Nocardioides Sp. SP1b Isolated from Agricultural Soil. Int. Biodeterior. Biodegrad. 2017, 118, 1–9. [Google Scholar] [CrossRef]
- Kumar, M.; Yadav, A.N.; Saxena, R.; Paul, D.; Tomar, R.S. Biodiversity of Pesticides Degrading Microbial Communities and Their Environmental Impact. Biocatal. Agric. Biotechnol. 2021, 31, 101883. [Google Scholar] [CrossRef]
- Tang, T.; Zhang, Y.; Cai, T.; Deng, X.; Liu, C.; Li, J.; He, S.; Li, J.; Wan, H. Antibiotics Increased Host Insecticide Susceptibility via Collapsed Bacterial Symbionts Reducing Detoxification Metabolism in the Brown Planthopper, Nilaparvata lugens. J. Pest Sci. 2021, 94, 757–767. [Google Scholar] [CrossRef]
- González-Tokman, D.; Córdoba-Aguilar, A.; Dáttilo, W.; Lira-Noriega, A.; Sánchez-Guillén, R.A.; Villalobos, F. Insect Responses to Heat: Physiological Mechanisms, Evolution and Ecological Implications in a Warming World. Biol. Rev. 2020, 95, 802–821. [Google Scholar] [CrossRef]
- Li, W.Z.; Zhu, T.; Zhou, J.J.; Shang, S.Q. Effects of Short-Term Heat Stress on the Activity of Three Antioxidant Enzymes of Predatory Mite Neoseiulus barkeri (Acari, Phytoseiidae). Front. Physiol. 2022, 13, 937033. [Google Scholar] [CrossRef] [PubMed]
- León-Quinto, T.; Serna, A. Cryoprotective Response as Part of the Adaptive Strategy of the Red Palm Weevil, Rhynchophorus ferrugineus, against Low Temperatures. Insects 2022, 13, 246. [Google Scholar] [CrossRef] [PubMed]
- Chen, H.; Solangi, G.S.; Zhao, C.; Yang, L.; Guo, J.; Wan, F.; Zhou, Z. Physiological Metabolic Responses of Ophraella communa to High Temperature Stress. Front. Physiol. 2019, 10, 1053. [Google Scholar] [CrossRef] [PubMed]
- Fontaine, S.S.; Kohl, K.D. The Microbiome Buffers Tadpole Hosts from Heat Stress: A Hologenomic Approach to Understand Host–Microbe Interactions under Warming. J. Exp. Biol. 2023, 226, jeb245191. [Google Scholar] [CrossRef] [PubMed]
- Tougeron, K.; Iltis, C.; Rampnoux, E.; Goerlinger, A.; Dhondt, L.; Hance, T. Still Standing: The Heat Protection Delivered by a Facultative Symbiont to Its Aphid Host Is Resilient to Repeated Thermal Stress. Curr. Res. Insect Sci. 2023, 3, 100061. [Google Scholar] [CrossRef] [PubMed]
- Fontaine, S.S.; Mineo, P.M.; Kohl, K.D. Experimental Manipulation of Microbiota Reduces Host Thermal Tolerance and Fitness under Heat Stress in a Vertebrate Ectotherm. Nat. Ecol. Evol. 2022, 6, 405–417. [Google Scholar] [CrossRef] [PubMed]
- Feng, Y.; Xu, L.; Li, W.; Xu, Z.; Cao, M.; Wang, J.; Tao, J.; Zong, S. Seasonal Changes in Supercooling Capacity and Major Cryoprotectants of Overwintering Asian Longhorned Beetle (Anoplophora glabripennis) Larvae. Agric. For. Entomol. 2016, 18, 302–312. [Google Scholar] [CrossRef]
- Saeidi, M.; Moharramipour, S. Physiology of Cold Hardiness, Seasonal Fluctuations, and Cryoprotectant Contents in Overwintering Adults of Hypera postica (Coleoptera: Curculionidae). Environ. Entomol. 2017, 46, 960–966. [Google Scholar] [CrossRef]
- Martin, M.M.; Cabello, T. Biología y Ecología Del Curculiónido Rojo de La Palmera, Rhynchophorus ferrugineus; Universidad de Almería: Almería, Spain, 2005; ISBN 84-689-5292-3. [Google Scholar]
- Malik, M.A.; Malik, F.A. Ontogenic Changes in Haemolymph Biochemical Composition in the Silkworm, Bombyx mori L. under Thermal Stress Division of Sericulture; Sher-e-Kashmir University of Agricultural Sciences and Technology, Department of Studies in Sericultural Science: Kashmir, India, 2009; Volume 2, pp. 16–21. [Google Scholar]
- Zhu, W.; Zhang, H.; Meng, Q.; Wang, M.; Zhou, G.; Li, X.; Wang, H.; Miao, L.; Qin, Q.; Zhang, J. Metabolic Insights into the Cold Survival Strategy and Overwintering of the Common Cutworm, Spodoptera litura (Fabricius) (Lepidoptera: Noctuidae). J. Insect Physiol. 2017, 100, 53–64. [Google Scholar] [CrossRef]
- Heydari, M.; Izadi, H. Effects of Seasonal Acclimation on Cold Tolerance and Biochemical Status of the Carob Moth, Ectomyelois ceratoniae Zeller, Last Instar Larvae. Bull. Entomol. Res. 2014, 104, 592–600. [Google Scholar] [CrossRef] [PubMed]
- Dmochowska, K.; Giejdasz, K.; Fliszkiewicz, M.; Żółtowska, K. Prolonged Postdiapause: Influence on Some Indicators of Carbohydrate and Lipid Metabolism of the Red Mason Bee, Osmia Rufa. J. Insect Sci. 2013, 13, 77. [Google Scholar] [CrossRef] [PubMed]
- Sadeghi, R.; Izadi, H.; Mahdian, K. Energy Allocation Changes in Overwintering Adults of the Common Pistachio Psylla, Agonoscena pistaciae Burckhardt & Lauterer (Hemiptera: Psyllidae). Neotrop. Entomol. 2012, 41, 493–498. [Google Scholar] [CrossRef]
- Ghaedi, B.; Andrew, N.R. The Physiological Consequences of Varied Heat Exposure Events in Adult Myzus persicae: A Single Prolonged Exposure Compared to Repeated Shorter Exposures. PeerJ 2016, 4, e2290. [Google Scholar] [CrossRef]
- Feng, T.; Wang, J. Oxidative Stress Tolerance and Antioxidant Capacity of Lactic Acid Bacteria as Probiotic: A Systematic Review. Gut Microbes 2020, 12, 1801944. [Google Scholar] [CrossRef]
- Rajoka, M.S.R.; Thirumdas, R.; Mehwish, H.M.; Umair, M.; Khurshid, M.; Hayat, H.F.; Phimolsiripol, Y.; Pallarés, N.; Martí-Quijal, F.J.; Barba, F.J. Role of Food Antioxidants in Modulating Gut Microbial Communities: Novel Understandings in Intestinal Oxidative Stress Damage and Their Impact on Host Health. Antioxidants 2021, 10, 1563. [Google Scholar] [CrossRef]
- Jena, K.; Kumar Kar, P.; Kausar, Z.; Babu, C.S. Effects of Temperature on Modulation of Oxidative Stress and Antioxidant Defenses in Testes of Tropical Tasar Silkworm Antheraea mylitta. J. Therm. Biol. 2013, 38, 199–204. [Google Scholar] [CrossRef]
- Yang, L.-H.; Huang, H.; Wang, J.-J. Antioxidant Responses of Citrus Red Mite, Panonychus citri (McGregor) (Acari: Tetranychidae), Exposed to Thermal Stress. J. Insect Physiol. 2010, 56, 1871–1876. [Google Scholar] [CrossRef] [PubMed]
- Sohal, R.S.; Arnold, L.; Orr, W.C. Effect of Age on Superoxide Dismutase, Catalase, Glutathione Reductase, Inorganic Peroxides, TBA-Reactive Material, GSH/GSSG, NADPH/NADP+ and NADH/NAD+ in Drosophila Melanogaster. Mech. Ageing Dev. 1990, 56, 223–235. [Google Scholar] [CrossRef]
- Nabizadeh, P.; Jagadeesh Kumar, T.S. Fat Body Catalase Activity as a Biochemical Index for the Recognition of Thermotolerant Breeds of Mulberry Silkworm, Bombyx mori L. J. Therm. Biol. 2011, 36, 1–6. [Google Scholar] [CrossRef]

| Phylum | Family | Genera | Species | Number (n = 70) | Distribution | Frequency (%) |
|---|---|---|---|---|---|---|
| Proteobacteria (61.4%) | Enterobacteriaceae (30%) | Enterobacter (25.7%) | Enterobacter aerogenes | 15 | L, F, M | 21.4 |
| Enterobacter mori | 3 | L | 4.3 | |||
| Klebsiella | Klebsiella pneumonia | 3 | L, F | 4.3 | ||
| Moraxellaceae | Acinetobacter | Acinetobacter lwoffii | 14 | L, F, M | 20 | |
| Morganellaceae | Morganella | Morganella morganii | 8 | L, F, M | 11.4 | |
| Firmicutes (21.5%) | Bacillaceae | Bacillus | Bacillus subtilis | 15 | L, F, M | 21.4 |
| Actinobacteria (17.1%) | Streptomycetaceae | Streptomyces | Streptomyces sp. | 8 | F, M | 11.4 |
| Micrococcaceae | Arthrobacter | Arthrobacter sp. | 4 | L | 5.8 |
| Isolates | GenBank Accession Number(s) | The Mean of Degradation Enzymes Clear Zone Indices | Growth and Mean Clear Zone Index in Media Supplemented with Pesticides (100 ppm) | |||||||
|---|---|---|---|---|---|---|---|---|---|---|
| CMC | Xylan | Starch | Pectin | Tween 80% | Gelatin | Chlorpyrifos | Emamectin Benzoate | λ-Cyhalothrin | ||
| Enterobacter aerogenes | OP023877 | 1.2 ± 0.1 | 0 | 1.1 ± 0.1 | 0 | 1.1 ± 0.1 | 0 | − | ++ (1.1±0.1) | ++ (1.1 ± 0.1) |
| Klebsiella pneumoniae | OP023878 | 0 | 0 | 0 | 1.1 ± 0.1 | 0 | 0 | − | + | ++ (1.1 ± 0.1) |
| Enterobacter mori | OP023883 | 0 | 0 | 3.5 ± 0.3 | 0 | 0 | 0 | + | ++ | + (1.1 ± 0.1) |
| Bacillus subtilis | OP023885 | 4.0 ± 0.1 | 1.2 ± 0.1 | 2.7 ± 0.1 | 1.2 ± 0.1 | 1.2 ± 0.8 | 1.1 ± 0.1 | + | ++ | ++ (1.2 ± 0.1) |
| Acinetobacter lwoffii | OP023886 | 3.5 ± 0.3 | 1.1 ± 0.1 | 1.4 ± 0.2 | 0 | 1.3 ± 0.2 | 0 | − | ++ | ++ (1.2 ± 0.0) |
| Arthrobacter sp. | OP023887 | 0 | 1.2 ± 0.1 | 1.2 ± 0.1 | 0 | 0 | 1.2 ± 0.1 | ++ (1.3 ± 0.2) | ++ (1.2 ± 0.1) | ++ (1.1 ± 0.5) |
| Morganella morganii | OP023888 | 0 | 0 | 4.0 ± 0.4 | 0 | 1.2 ± 0.6 | 0 | + | + | + |
| Streptomyces sp. | OP023894 | 1.35 ± 0.1 | 1.3 ± 0.1 | 1.4 ± 0.1 | 1.7 ± 0.3 | 2.0 ± 0.2 | 0 | + | ++ (1.2 ± 0.1) | ++ (1.1 ± 0.7) |
| Name | Exposure Time (Days) | Amount Recovered (ppm) | Amount Recovered (%) | Loss (%) |
|---|---|---|---|---|
| Arthrobacter sp. | Zero time | 15 | 100 | 0 |
| After 4 days | 5.83 | 44.7 | 55.29 | |
| After 10 days | 0.0 | 0.0 | 100 | |
| Control | Zero time | 15 | 100 | 0 |
| After 4 days | 13.04 | 100 | 0 | |
| After 10 days | 12.05 | 100 | 0 |
| LC15 (mg/L) (95% Confidence Limit) | LC50 (mg/L) (95% Confidence Limit) | Slope ± SE | χ2 |
|---|---|---|---|
| 8.347 (5.685–10.798) | 20.736 (16.624–26.717) | 2.6225 ± 0.379 | 3.265 |
| Isolates | GenBank Accession Number (s) | 15 °C | 27 °C | 35 °C | |||
|---|---|---|---|---|---|---|---|
| AF | CF | AF | CF | AF | CF | ||
| Enterobacter aerogenes | OP023877 | − | − | − | + | − | + |
| Klebsiella pneumoniae | OP023878 | + | + | + | + | + | + |
| Enterobacter mori | OP023883 | − | − | − | + | − | − |
| Bacillus subtilis | OP023885 | − | + | − | + | − | + |
| Acinetobacter lwoffii | OP023886 | − | − | − | + | − | + |
| Arthrobacter sp. | OP023887 | − | − | − | + | − | − |
| Morganella morganii | OP023888 | + | + | + | + | + | + |
| Streptomyces sp. | OP023894 | − | − | − | + | − | − |
Disclaimer/Publisher’s Note: The statements, opinions and data contained in all publications are solely those of the individual author(s) and contributor(s) and not of MDPI and/or the editor(s). MDPI and/or the editor(s) disclaim responsibility for any injury to people or property resulting from any ideas, methods, instructions or products referred to in the content. |
© 2024 by the authors. Licensee MDPI, Basel, Switzerland. This article is an open access article distributed under the terms and conditions of the Creative Commons Attribution (CC BY) license (https://creativecommons.org/licenses/by/4.0/).
Share and Cite
Elkraly, O.A.; Elrahman, T.A.; Awad, M.; El-Saadany, H.M.; Atia, M.A.M.; Dosoky, N.S.; Ibrahim, E.-D.S.; Elnagdy, S.M. Exploring Gut Microbiota in Red Palm Weevil (Rhynchophorus ferrugineus): Effects on Pest Management, Pesticide Resistance, and Thermal Stress Tolerance. Microbiol. Res. 2024, 15, 1359-1385. https://doi.org/10.3390/microbiolres15030092
Elkraly OA, Elrahman TA, Awad M, El-Saadany HM, Atia MAM, Dosoky NS, Ibrahim E-DS, Elnagdy SM. Exploring Gut Microbiota in Red Palm Weevil (Rhynchophorus ferrugineus): Effects on Pest Management, Pesticide Resistance, and Thermal Stress Tolerance. Microbiology Research. 2024; 15(3):1359-1385. https://doi.org/10.3390/microbiolres15030092
Chicago/Turabian StyleElkraly, Omnia Abdullah, Tahany Abd Elrahman, Mona Awad, Hassan Mohamed El-Saadany, Mohamed A. M. Atia, Noura S. Dosoky, El-Desoky S. Ibrahim, and Sherif M. Elnagdy. 2024. "Exploring Gut Microbiota in Red Palm Weevil (Rhynchophorus ferrugineus): Effects on Pest Management, Pesticide Resistance, and Thermal Stress Tolerance" Microbiology Research 15, no. 3: 1359-1385. https://doi.org/10.3390/microbiolres15030092
APA StyleElkraly, O. A., Elrahman, T. A., Awad, M., El-Saadany, H. M., Atia, M. A. M., Dosoky, N. S., Ibrahim, E.-D. S., & Elnagdy, S. M. (2024). Exploring Gut Microbiota in Red Palm Weevil (Rhynchophorus ferrugineus): Effects on Pest Management, Pesticide Resistance, and Thermal Stress Tolerance. Microbiology Research, 15(3), 1359-1385. https://doi.org/10.3390/microbiolres15030092









